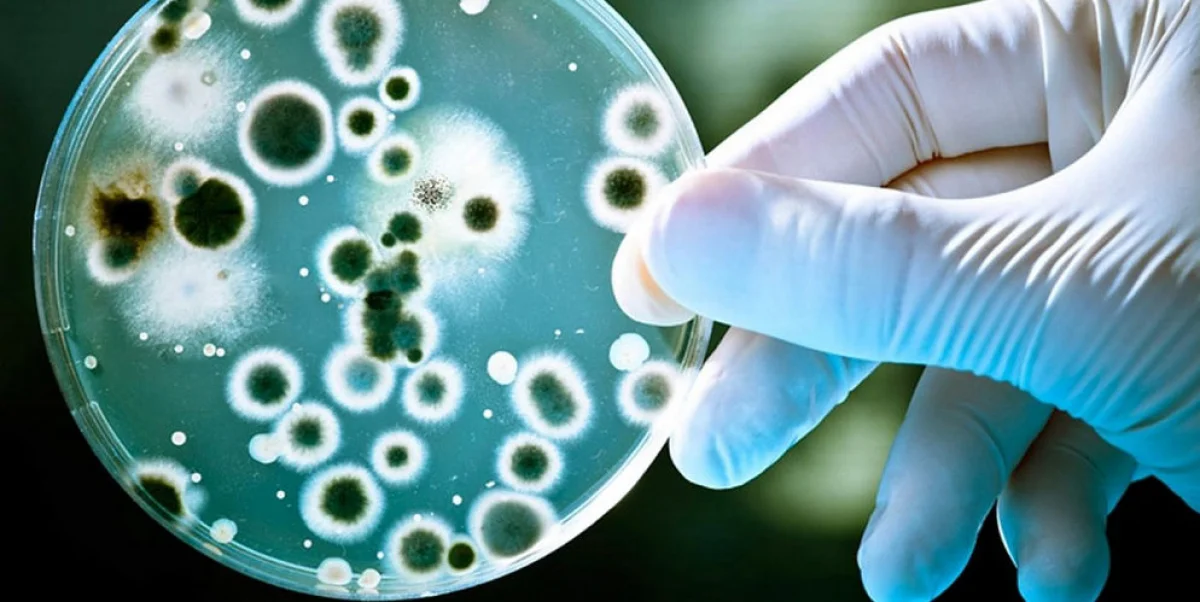
_фото из открытых источников

С начала года в Мангистауской области наблюдается подъем заболеваемости бруцеллезом. По сравнению с аналогичным показателем прошлого года рост отмечен в 2,3 раза. Об этом рассказала Мадина Рахметова, главный специалист отдела эпидемиологического надзора за особо опасными инфекциями и туберкулезом регионального департамента санитарно-эпидемиологического контроля.
По итогам 5 месяцев 2024 года в Мангистауской области выявлено семь случаев бруцеллеза.
«Этот показатель по сравнению с аналогичным периодом 2023 года вырос на четыре факта, то есть вырос в 2,3 раза. По результатам многолетней экспертной работы выяснилось, что больные бруцеллезом - это жители сельской местности, имеющие непосредственный контакт с больными животными. Они заразились при использовании термически необработанных мясомолочных продуктов», - прокомментировала Мадина Рахметова.
Что такое бруцеллез?
Это тяжелое, трудно поддающееся лечению инфекционное заболевание, поражающее опорно-двигательную, суставы, нервную, сердечно-сосудистую системы, зачастую приводящее к инвалидизации.
Каковы источники заражения?
Это только больные животные (овцы, козы, крупный рогатый скот, свиньи и т.д.). Бруцеллез передается людям при несоблюдении мер предосторожности при уходе за животными и при использовании мяса и молочных продуктов больных животных.
Каковы меры профилактики?
При уходе за животными необходимо носить резиновые сапоги, перчатки, специальные халаты, фартуки/косынки, которые нужно стирать отдельно от остальной одежды, после проведенных работ по уходу за животными тщательно мыть руки. Очищать скотный двор от навоза, так как возбудитель сохраняется в навозе в течение полугода, проводить профилактическую дезинфекцию средствами, разрешенными в Республике Казахстан. Не покупать на улице молоко, сметану и мясо, ведь все эти продукты можно купить на рынке, где они проходят ветеринарный контроль.
Каковы симптомы бруцеллеза?
При заболевании бруцеллезом больной отмечает повышение температуры тела (выше 37,5°С – пять дней и более), общую слабость, быструю утомляемость, головную боль, нарушение сна, озноб, потливость, у больных наблюдаются боли в суставах, мышцах и пояснице. При появлении указанных симптомов необходимо обратиться в медицинское учреждение для своевременного получения квалифицированной помощи. Отсутствие лечения приведет к осложнениям, таким как нарушение детородной функции (как у женщин, так и у мужчин), поражения нервной, опорно-двигательной и сердечно-сосудистой систем и в итоге к инвалидности.
«Владельцам животных необходимо серьезно относится к ветеринарному и лабораторному обследованию скота, особенно молочного поголовья. Учитывая, что заражение бруцеллезом происходит от больного скота, необходимо выявление и ликвидация больных животных, уничтожение микробов во внешней среде (дезинфекция), термическая обработка мясо-молочной продукции (молоко - после кипячения, мясо - после варки небольшими кусками в течение трех часов, при разделке мяса использовать перчатки», - отметила главный специалист.
Комментарии
0 комментарий(ев)